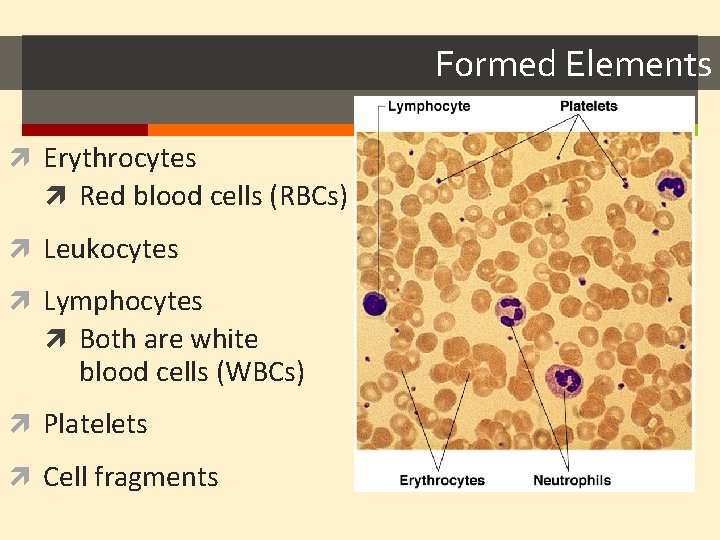
Formed Elements Erythrocytes Red blood cells (RBCs) Leukocytes Lymphocytes Both are white blood cells

Chapter 10 Blood Blood The only fluid tissue

Chapter 10: Blood

Blood The only fluid tissue in the body Classified as a connective tissue Notable: collagen & elastin absent from blood Dissolved fibrin proteins become evident during clotting Components of blood Living cells Formed elements – RBC & WBC Non-living matrix Plasma

When Blood is centrifuged Plasma rises to the top (55%) Erythrocytes sink to the bottom (45%)5 This is known as the hematocrit Normal hematocrit: 47% +/- 5%: males 42% +/-5%: females Buffy coat contains leukocytes & platelets (<1%) Thin, whitish layer that is between erythrocytes & plasma

Physical Characteristics of Blood Sticky, opaque fluid – metallic taste More dense than water, 5 x more viscous Colors: Oxygen rich blood – scarlet red (bright) Oxygen poor blood – dull red p. H is between 7. 35 – 7. 45 Blood temperature is always slightly higher than body temperature – around 100. 4 F In a healthy man, blood volume is about 5 -6 liters or about 6 quarts Women have less blood, about 3. 5 – 5 liters Blood makes up about 8% of body weight

Functions of Blood All concerned with: substance distribution regulating blood levels of particularly substances bodily protection Distribution: Oxygen to lungs Nutrients to digestive system Transporting metabolic wastes from elimination sites (lungs, kidneys, liver) Hormones from glands to target organs

Functions of Blood Regulation: Maintain appropriate body temperature by absorbing and distributing heat through body, encouraging skin for heat loss Maintain normal p. H, blood holds an “alkaline” reserve to raise p. H when necessary Maintain adequate fluid volume in circulation Salts & blood protein – prevent excess fluid loss Protection Prevents blood loss Prevents infection

Blood Plasma Straw colored, sticky liquid Composed of approximately 90% water Includes over 100 dissolved substances: Nutrients Salts (electrolytes) Respiratory gases (CO 2 & O 2) Hormones Plasma proteins Waste products Uric acid, creatinine, lactic acid, ammonium salts

Blood Plasma: Plasma Proteins Most abundant solutes in plasma Made mostly by the liver Proteins include: Albumin: regulates osmotic pressure The pressure that keeps water in the blood Essentially carries all proteins around the blood High albumin almost always caused by dehydration Low albumin can come from liver disease, kidney disease, & malnutrition Globulins: Alpha, beta: transport proteins that bind to lipids, metal ions, fat-soluble vitamins Gamma: antibodies released during an immune response Clotting proteins: help to stop blood loss when a blood vessel is injured Antibodies: help protect the body from pathogens (disease)

Blood Plasma Acidosis: blood becomes too acidic Liver failure, kidney failure Alkalosis: blood becomes too basic Main cause: hyperventilation – resulting in a loss of CO 2 Other causes: prolonged vomiting, Cushing’s syndrome, severe dehydration In each scenario, the respiratory system & kidneys help restore blood p. H to normal
Formed Elements Erythrocytes Red blood cells (RBCs) Leukocytes Lymphocytes Both are white blood cells (WBCs) Platelets Cell fragments

Erythrocytes AKA Red blood cells (RBCs) Formed Elements 4 -6 million (per mm 3) Developed in the bone marrow Salmon – colored biconcave discs Anucleate – CAN’T reproduce–produced in the bone marrow Literally, sacs of hemoglobin most organelles have been rejected Structural protein called spectrin: spectrin net is deformable – allows erthyrocytes to change shape as necessary to move through blood vessels Each erythrocyte has 250 million hemoglobin sacs Normal blood contains 12 -18 g per 100 ml of blood Functions: Transport oxygen to lung capillary beds Also transports small amounts of CO (about 20%)

Formed Elements Erythrocytes Women have lower RBC count (4. 32 -5, versus 5. 1 – 5. 8 mm 3) As RBCs increase, blood viscosity increases, blood flow slows Function: Respiratory gas transport Hemoglobin in RBC binds to oxygen 14 -20 (g/100 ml) – infants 13 -18 – adult males 12 – 16 – adult females Hemoglobin is inside RBCs to prevents the protein molecule from breaking apart and leaking through the bloodstream

Formed Elements Diseases of RBCs Anemia Decrease in oxygen carrying ability Sickle cell anemia (SCA) abnormally shaped hemoglobin Genetically caused Painful condition Polycythemia excessive or abnormal increase in the number of RBCs

Formed Elements

Formed Elements: Leukocytes Essential for body’s defense against pathogens Complete cells with a nucleus & organelles Can move in/out of blood vessels on their own (diapedesis) Move with ameboid motion Respond to chemicals released by damaged tissues 4, 000 – 11, 000 per mm 3 of blood

Formed Elements: Types of Leukocytes Hemocytoblast stem cells Granulocytes Lymphoid Myeloid stem cells Possess lobed nuclei Will show granules in cytoplasm when stained Secondary stem cells Include: neutrophils, eosinophils, & basophils Agranulocytes Lack of visible granules Nuclei are spherical, Erythrocytes oval or kidney – shaped Include: lymphocytes & monocytes Basophils List of the WBCs from most to least abundant Platelets Neutrophils Lymphocytes Monocytes Eosinophils Basophils Lymphocytes Never Let Monkeys Eat Bananas Monocytes Eosinophils Neutrophils

Formed Elements: Types of Leukocytes Neutrophils Multilobed nuclei with small granules Acts as phagocyte at active site of infection “first responder” to inflammatory site (trauma) – tell tale sign of acute inflammation Eosinophils Large brick red granules Shown in response to allergies, asthmatic reactions or parasitic worms May play a role in defense against viruses

Formed Elements: Types of Leukocytes Basophils Least common granulocytes Contain histamine granules Initiate inflammation Contain heparin Prevent blood from clotting too quickly May regulate the behavior of T cells

Formed Elements: Types of Agranulocytes Lymphocytes Nucleus fills most of the cell Plays an important role in the immune system Types of Lymphocytes: Killer Cells (Killer T Cells) Defend against tumors and virally infected cells T Cells (Thymus Cells) Many subsets of t cells All cell mediated immunity – pathogen detection B Cells (Bone cells) Secretion of antibodies Neutralize foreign objects like bacteria & viruses

Formed Elements: Types of Agranulocytes Monocytes Largest WBC in size ~50% found in the spleen Function as macrophages Specific & non-specific defense Act in response to inflammatory situations to get rid of pathogen/allergic causing antigen Important in fighting chronic infection

WBC Abnormalities Leukocytosis WBC count above 11, 000 leukocytes/mm 3 Generally indicates an infection But not indicative of any specific infection It’s diagnostically similar to a fever Leukopenia Abnormally low leukocyte level Commonly caused by certain drugs such as corticosteroids and anticancer agents An important indicator of infection risk Leukemia Bone marrow becomes cancerous, turns out excess WBC 4 types: ALL (acute lymphoblastic), CLL, AML (acute myelogenous), & CML Can be acute or chronic Acute is more common in children, chronic in the elderly Can be lymphoid or myeloid Lymphoid is more common in children, myeloid is rare in children http: //www. youtube. com/watch? v=t. DTLC 2 swhl. Q

Aka thrombocytes Formed Elements: Platelets Small regular shaped cell fragments, derived from megakaryocytes (bone marrow cell) Average lifespan of a platelet is 5 to 9 days Needed for the clotting process If platelets are too low, excessive bleeding can occur; if too high, wanted/unwanted clotting can occur.

Hematopoiesis Blood cell formation in red bone marrow All blood cells (red & white) derive from a common stem cell (hemocytoblast) Differentation: Lymphoid stem cells produce lymphocytes Myeloid stem cell produces all other formed elements These stem cells are self-renewing I. e. – some never develop into RBCs or WBCs – they stay stem cells so they can mitotically divide into more stem cells.

Erthyrocyte formation I mb alato divide, grow & synthesize proteins Erthyrocytes are unable nce Normal blood oxygen levels Wear out in 100 – 120 days Imb Stimulus: Decreased RBC count, decreased availability of O 2 to blood, or increased tissue demands for O 2 ala ncremoved When they are no longer usable, they will be by e Increased O 2 - carrying ability of blood phagocytosis by the liver or spleen Lost cells are replaced by hemocytoblasts Reduced O 2 levels in blood Rate Moreof RBC production is controlled by the hormone erthyropoietin RBCs releases Kidneys produce most erythropoietin as a response to Kidney reduced erythropoietin Enhanced erythropoiesis oxygen levels in the blood Red bone marrow Erythropoietin stimulates Homeostasis is maintained by negative feedback from blood oxygen levels

Formation of WBCs and platelets Controlled by hormones Colony stimulating factors (CSFs) and interleukins prompt bone marrow to generate leukocytes Thrombopoietin stimulates production of platelets

Hemostasis Stoppage of bleeding resulting from a break in a blood vessel Hemostasis involves three phases Vascular spasms Vasoconstriction causes the blood vessel to spasm Spasms narrow the blood vessel and decreases overall blood loss

Hemostasis Platelets release chemicals Platelet formation thatplug attract more platelets to the site and make nearby Collagen fibers that make up the blood vessel become exposed by the platelets sticky break PF from Platelets become sticky & cling to the collagen fibers Calcium platelets 3 and other Those platelets release chemicals (PF 3) to attract more platelets clotting + factors The platelets pile up to form a platelet plug in blood Tissue factor in damaged tissue plasma Coagulation (blood clotting) Injured tissues release TF (tissue factor) Phases of Formation of coagulation PF interacts with TF, clotting factors & calcium ions to initiate the prothrombin (clotting 3 cascade) clotting activator cascade Prothrombin gets converted to thrombin by prothrombin activator. Prothrombin Thrombin joins fibrinogen proteins into hair-like molecules of insoluble Fibrinogen Fibrin fibrin (soluble) (insoluble) Fibrin forms a meshwork (the basis for a clot)

Hemostasis Blood usually clots within 3 to 6 minutes The clot remains as endothelium regenerates The clot is broken down after tissue repair

Undesirable Clotting Thrombus A clot in an unbroken blood vessel – normal during injury but should be disposed of once the risk of excessive bleeding has past. Can be deadly in areas like the heart More likely to occur when there are problems in the heart (arrhythmia, heart valve replacement and/or recent heart attack Embolus A thrombus that breaks away and floats freely in the bloodstream In general, an embolus is ANY detached, itinerant intravascular mass – they can be solid, liquid or gas Can later clog vessels in critical areas such as the brain

Bleeding Disorders Thrombocytopenia Platelet deficiency = below 50, 000 per microliter Normal platelet counts are between 150, 000 – 450, 000 per microliter of blood (that’s a lot) Even normal movements can cause bleeding from small blood vessels that require platelets for clotting Symptoms include frequent bruising, purpura, & petechiae

Bleeding Disorders Haemophilia Hereditary bleeding disorder Normal clotting factors are missing When bleeding occurs, a scab does form, but it is temporary The clotting factor prevents the fibrin from reattaching and healing the blood vessel

Blood Typing & Transfusions Large losses of blood have serious consequences Loss of 15– 30% causes weakness Loss of over 30% causes shock, which can be fatal Transfusions are the only way to replace blood quickly Transfused blood must be of the same blood group Blood is tested for a large number of diseases before giving to the patient who needs blood Tested for: All forms of HIV, All forms of hepatitis, syphillis, CMV, and West Nile virus – just to name a few Complications: Hemolytic reactions: you have antibodies again the donor’s RBCs – symptoms include fever, chills, increased heart rate, shortness of breath, rapid drop in blood pressure. Transfusion must be stopped immediately before kidney damage occurs Allergic reactions: while blood banks look at the complete chemical make up of donor blood, if a patient is unaware of allergies and these chemicals are in blood – an allergic reaction can occur If severe, Usually easily fixed by dosing epinephrine to stop anaphylaxis

Human Blood Groups Blood contains genetically determined proteins Antigens (a substance the body recognizes as foreign) may be attacked by the immune system Antibodies are the “recognizers” Blood is “typed” by using antibodies that will cause blood with certain proteins to clump (agglutination) There are over 30 common red blood cell antigens The most vigorous transfusion reactions are caused by ABO and Rh blood group antigens

ABO Blood Groups Based on the presence or absence of two antigens Type A: The presence of antigen A, has anti-B antibodies Type B: The presence of antigen B, has anti-A antibodies Type O: lacks the presence of any antigens, has anti-A & anti -B antibodies Type AB: the presence of antigen A & antigen B, has no antibodies

ABO Blood Groups Blood type AB can receive A, B, AB, and O blood Universal recipient Blood type B can receive B and O blood Blood type A can receive A and O blood Blood type O can receive O blood Universal donor

Rh Blood Groups Named because of the presence or absence of one of eight Rh antigens (agglutinogen D) that was originally defined in Rhesus monkeys Most Americans are Rh+ (Rh positive) Problems can occur in mixing Rh+ blood into a body with Rh– (Rh negative) blood

Dangers of an Rh mismatch Danger occurs only when the mother is Rh– and the father is Rh+, and the child inherits the Rh+ factor Rho. GAM shot can prevent buildup of anti-Rh+ antibodies in mother’s blood The mismatch of an Rh– mother carrying an Rh+ baby can cause problems for the unborn child The first pregnancy usually proceeds without problems The immune system is sensitized after the first pregnancy In a second pregnancy, the mother’s immune system produces antibodies to attack the Rh+ blood (hemolytic disease of the newborn)

Blood typing Blood samples are mixed with anti-A and anti-B serum Agglutination or no agglutination leads to determining blood type Typing for ABO and Rh factors is done in the same manner Cross matching—testing for agglutination of donor RBCs by the recipient’s serum, and vice versa

Developmental Aspects of Blood Sites of blood cell formation The fetal liver and spleen are early sites of blood cell formation Bone marrow takes over hematopoiesis by the seventh month Fetal hemoglobin differs from hemoglobin produced after birth It can carry much more oxygen than adult hemoglobin By 12 weeks of life, fetal hemoglobin is replaced by adult hemoglobin Physiologic jaundice results in infants in which the liver cannot rid the body of hemoglobin breakdown products fast enough
- Slides: 39